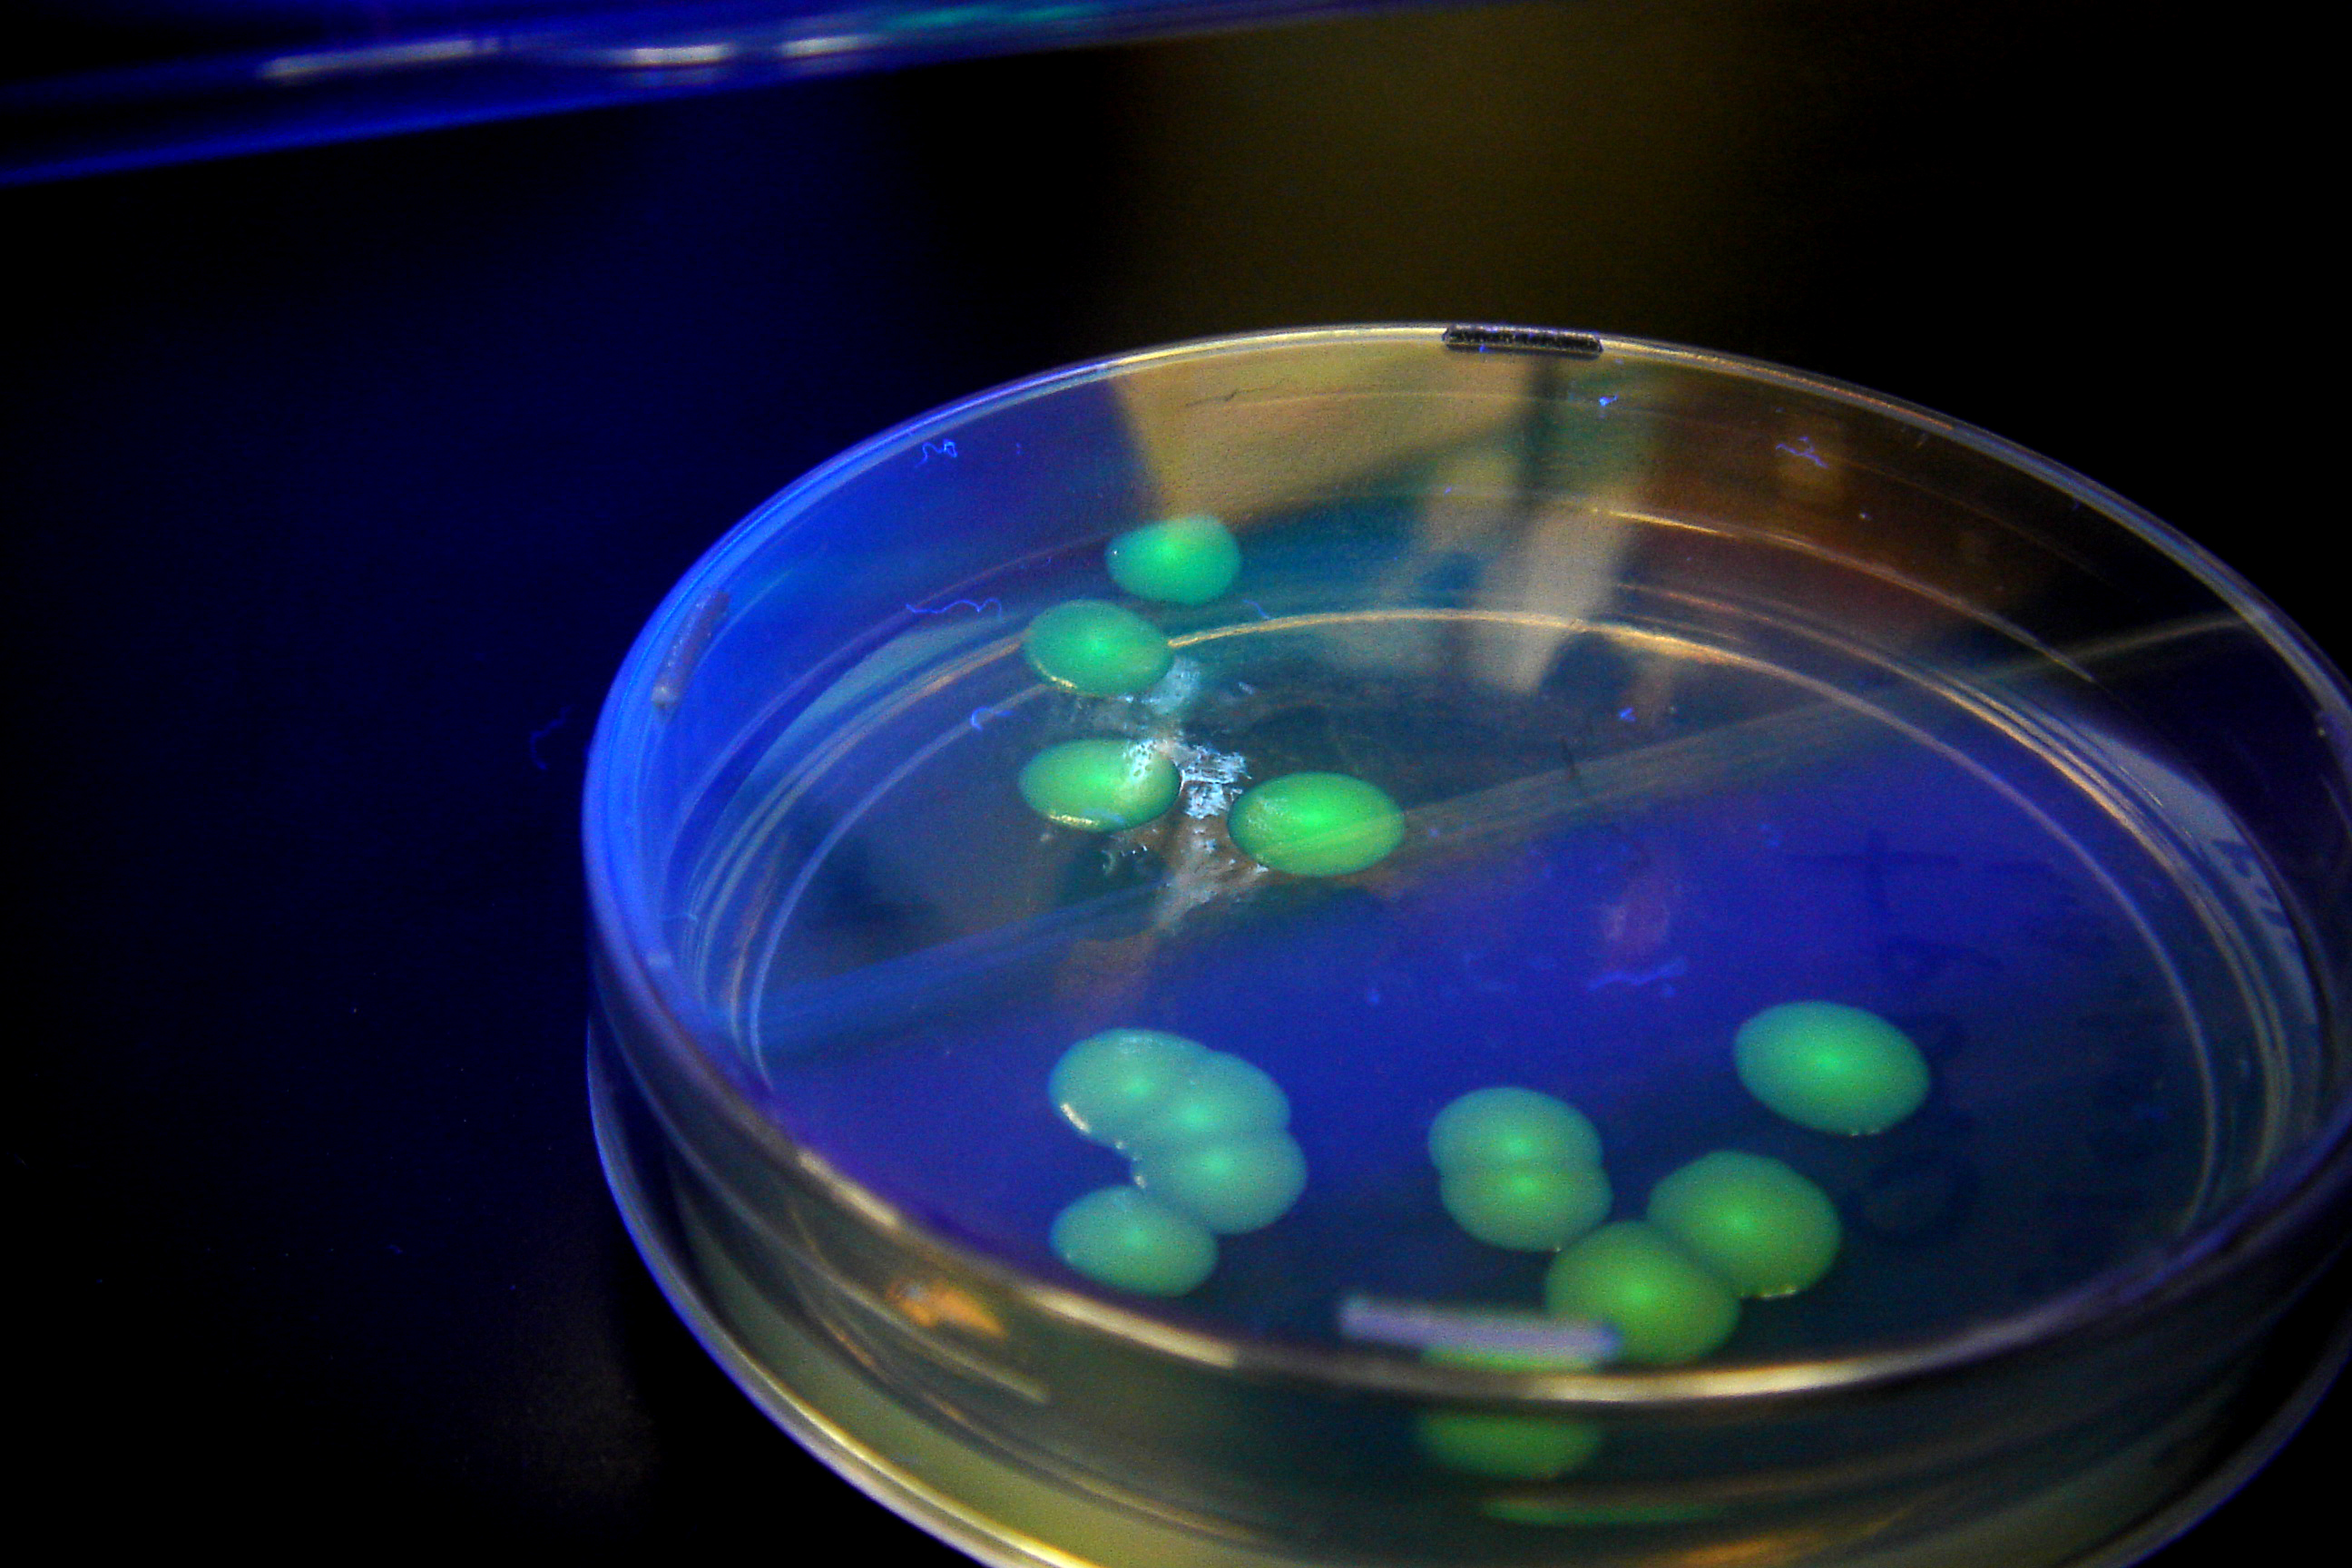
Random image

.png) 2023 Nissan Z Proto Spec (Automatic).png |
○
 Christmas Lights |
○
 Coral on the Beach |
○
 Crawfish |
○
 Fay, the Frog |
○
 Filtered Sunset |
○
Fluorescent Bacteria Farm |
○
 Lava Lamp |
○
 Light Painting |
○
 Lower Antelope Canyon |
○
 Lunar Luminescence |
○
 Magnified Spider |
○
 Mt. Fuji |
○
 Peacock Tail |
○
 Pink Lotus |
○
 Rainbow Crystal Point |
○
 Rising Flowers |
○
 The Waters |
○
.jpg) Tube Anemone (Cerianthus sp.) |
○
 What Are Real Colors |
○
| ○ |
| ○ |